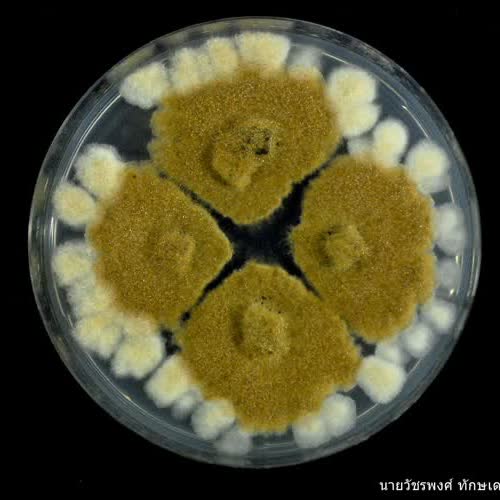

4 สหาย

148
264

4 สหาย ได้รับใบอนุญาตภายใต้ ให้เผยแพร่-โดยต้องระบุที่มาแต่ห้ามดัดแปลงและห้ามใช้เพื่อการค้า 3.0 Thailand.
ไฟล์ดิจิทัล
| ชื่อเรื่อง : 4 สหาย |
|
ชื่อเรื่อง :
|
| คำอธิบาย : Cylindrocladium sp. เป็นเชื้อที่ย่อยซากพืช สร้างโคโลนีที่มีลักษณะ ตรงกลางมีสีน้ำตาล ปลายโคโลนีสีขาวครีม |
| คำอธิบาย : |
| คำสำคัญ : เห็ด, Cylindrocladium sp., รา, พืช, ภาพถ่าย |
|
คำสำคัญ :
|
| ผู้สร้างสรรค์/ผู้แต่ง/เจ้าของผลงาน : วัชรพงศ์ ทักษเดช |
|
ผู้สร้างสรรค์/ผู้แต่ง/เจ้าของผลงาน :
|
| ผู้แต่งร่วม : โครงการ BRT |
|
ผู้แต่งร่วม :
|
| สื่อสำหรับบุคคลประเภท : ผู้ปกครอง, ครู / อาจารย์, ทั่วไป, นักเรียน / นักศึกษา |
|
สื่อสำหรับบุคคลประเภท :
ไม่พบข้อมูล
|
|
ระดับชั้น :
ประถมศึกษาปีที่ 1 (ป. 1), ประถมศึกษาปีที่ 2 (ป. 2), ประถมศึกษาปีที่ 3 (ป. 3), ประถมศึกษาปีที่ 4 (ป. 4), ประถมศึกษาปีที่ 5 (ป. 5), ประถมศึกษาปีที่ 6 (ป. 6), มัธยมศึกษาปีที่ 1 (ม. 1), มัธยมศึกษาปีที่ 2 (ม. 2), มัธยมศึกษาปีที่ 3 (ม. 3), มัธยมศึกษาปีที่ 4 (ม. 4), มัธยมศึกษาปีที่ 5 (ม. 5), มัธยมศึกษาปีที่ 6 (ม. 6), ปริญญาตรี , ปริญญาโท, ปริญญาเอก, ประกาศนียบัตรวิชาชีพ (ปวช.) , ประกาศนียบัตรครูเทคนิคชั้นสูง (ปทส.) , ประกาศนียบัตรวิชาชีพชั้นสูง (ปวส.), การศึกษาตามอัธยาศัย
|
|
ระดับชั้น :
ไม่พบข้อมูล
|
| สาขาวิชาของสื่อ : วิทยาศาสตร์ |
|
สาขาวิชาของสื่อ :
ไม่พบข้อมูล
|
| ลักษณะของสื่อ : รูปภาพ |
|
ลักษณะของสื่อ :
|
| URL : - |
| URL : |
| : |
วัชรพงศ์ ทักษเดช, โครงการ BRT.
(2563). 4 สหาย,
14 มกราคม 2563.
https://oer.learn.in.th/search_detail/result/163730
วัชรพงศ์ ทักษเดช, โครงการ BRT.
(2563). "4 สหาย".
https://oer.learn.in.th/search_detail/result/163730.
(14 มกราคม 2563)
วัชรพงศ์ ทักษเดช, โครงการ BRT.
"4 สหาย".
14 มกราคม 2563:
https://oer.learn.in.th/search_detail/result/163730.
ทรัพยากรที่เกี่ยวข้อง
ไม่มีเรื่องที่เกี่ยวข้อง
รีวิว : 4 สหาย
ไม่พบข้อมูลการรีวิว
 คลังทรัพยากรการศึกษาแบบเปิด
คลังทรัพยากรการศึกษาแบบเปิด